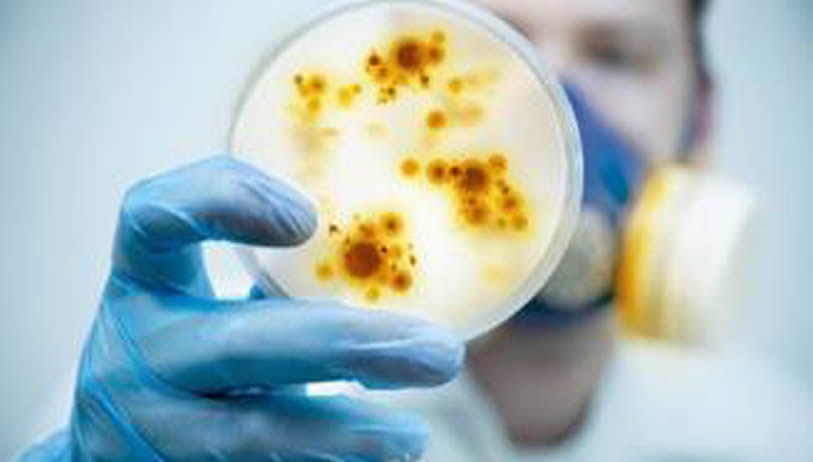

RPM for Primary Care Patients
RPM for Primary Care Patients
Can these codes be billed incident to? Yes. CMS announced in a technical correction on March 14, 2019, that RPM could be billed as “incident to” the billing practitioners services. This crucial change allows RPM services to be delivered by auxiliary personnel but, unlike in CCM described below, those auxiliary personnel must still be under the direct supervision of the physician. In practice, this means the physician must be in the same building at the same time as the auxiliary staff delivering the RPM service, though they do not have to be in the same room.
Are there geographic restrictions? No. RPM is not considered a telehealth service. Therefore there are no geographical or originating site restrictions
- Can the patient be at home? Yes.
- Do we need consent? Yes. The patient must give consent.
- Does there need to be face-to-face interaction? Only if the patient is new or has not been seen by their provider for greater than one year. In that case, the provider must conduct a face-to-face visit with the patient. This visit would be reimbursable under evaluation and management (E/M) visits
(CPT 99212 through 99215)

RPM for Primary Care Patients
RPM for Primary Care Patients The Home Care Industry
The Home Care Industry Preventing Readmission
Preventing Readmission TCM (Transitional Care Management)
TCM (Transitional Care Management)